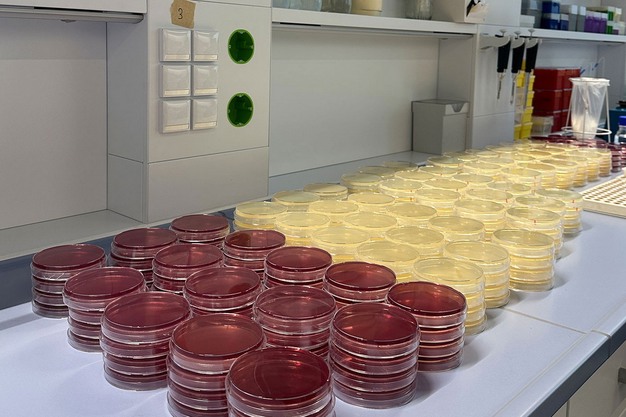

© FOOD freshly AFC GmbHFood freshly, lo specialista nel prolungamento della durata di conservazione dei prodotti ortofrutticoli, ha annunciato l'introduzione di due progetti innovativi per il 2026, sviluppati per combattere le perdite evitabili di lamponi, meloni, mirtilli, ananas e altri frutti e fornire servizi di test di efficacia più ampi per un'intera gamma di soluzioni post-raccolta.
© FOOD freshly AFC GmbHFood freshly, lo specialista nel prolungamento della durata di conservazione dei prodotti ortofrutticoli, ha annunciato l'introduzione di due progetti innovativi per il 2026, sviluppati per combattere le perdite evitabili di lamponi, meloni, mirtilli, ananas e altri frutti e fornire servizi di test di efficacia più ampi per un'intera gamma di soluzioni post-raccolta.
Nella foto a destra: screenshot di un report sulla shelf life del melone Cantalupo in un test di laboratorio di Food freshly
Il primo progetto è un'ambiziosa espansione del Food freshly Produce Wash, una soluzione lanciata a Fruit Logistica dello scorso anno, ma che ha ampliato il proprio campo di applicazione in risposta alla domanda dei clienti per includere piccoli frutti, ananas, meloni Cantalupo e ortaggi a radice.
Il secondo annuncio riguarda l'introduzione di nuovi servizi di analisi di laboratorio per frutta e verdura di IV gamma, disponibili per testare l'efficacia di qualsiasi soluzione e prodotto post-raccolta, non solo per quelli forniti da Food freshly. Grazie alle strutture di laboratorio di nuova inaugurazione ed estremamente complete, il team di Food freshly è in grado di esaminare come diversi prodotti e varietà reagiscono ai trattamenti post-raccolta.
© FOOD freshly AFC GmbHTest su mirtilli
© FOOD freshly AFC GmbHTest su mirtilli
Benjamin Singh, direttore tecnico commerciale e CEO di Food freshly, ha dichiarato: "Ci stiamo espandendo in ogni area possibile che possa essere di beneficio per i nostri clienti. Un esempio è il Produce Wash, su cui abbiamo lavorato per poter trattare prodotti molto difficili, come mirtilli, lamponi, meloni Cantalupo e ananas. Abbiamo collaborato con coltivatori e trasformatori per capire quali frutti causassero loro problemi e abbiamo scoperto che i piccoli frutti erano un settore chiave in cui avevano bisogno di assistenza. La gente li compra al supermercato e dopo un paio di giorni sono pieni di muffa: il settore ha dovuto affrontare questa difficoltà".
Il Produce Wash riunisce per la prima volta due lavaggi che si completano perfettamente a vicenda, preservando e proteggendo la qualità e l'integrità del prodotto durante il processo. Mentre un lavaggio rimuove efficacemente batteri, lieviti e muffe potenzialmente dannosi, il secondo consente alle aziende di sfruttare la comprovata esperienza di Food freshly nel prolungamento della durata di conservazione.
 © FOOD freshly AFC GmbHIl team Food freshly a Fruit Logistica 2025
© FOOD freshly AFC GmbHIl team Food freshly a Fruit Logistica 2025
Invece di ricorrere al lavaggio con sostanze chimiche, come il cloro e il peracetico, che in alcuni Paesi non sono consentite, il Produce Wash utilizza solo materiali di qualità alimentare autorizzati dalla legislazione dell'Ue sugli additivi e dalla FDA statunitense (GRAS).
Un altro settore in cui Food Freshly sta aiutando con il Produce Wash è quello degli ortaggi a radice. "Coltiviamo carote in pieno campo, che è pieno di batteri, funghi e muffe, e il lavaggio con acqua non sempre è sufficiente per pulirle adeguatamente", ha spiegato Singh. "Esiste anche un limite legale all'uso di prodotti chimici; questo non è il caso del Produce Wash, che utilizza ingredienti alimentari approvati in tutto il mondo".
Valutazione dei trattamenti post-raccolta
Grazie a uno staff di grande esperienza e a strutture di laboratorio all'avanguardia, Food freshly sta ampliando l'ambito delle sue strutture di degustazione post-raccolta per includere anche prodotti provenienti da altre fonti, oltre a quelli di Food freshly stessa.
Singh ha dichiarato: "Siamo in grado di coprire qualsiasi applicazione richiesta dal cliente e di costruire un quadro completo che ci indichi l'aspetto del prodotto, il livello di contaminazione microbica del terreno a cui è stato sottoposto e come i diversi trattamenti post-raccolta influiranno sulla durata di conservazione e sulle qualità organolettiche. Siamo in grado di rispondere a molte domande che i clienti potrebbero avere".
"Dedicato specificatamente a frutta e verdura di IV gamma, il nostro servizio è in grado di rispondere a domande che, per quanto ne possa sapere, nessun altro servizio simile è stato in grado di offrire: ad esempio come reagisce la frutta di IV gamma al confezionamento in atmosfera modificata", ha concluso Singh.
FOOD freshly sta attualmente effettuando prove con il Produce Wash per clienti in Spagna, Paesi Bassi e Regno Unito.
FOOD freshly sarà presente alla Fruit Logistica 2026 dal 4 al 6 febbraio: Hall 21, Stand E-50.
 Per maggiori informazioni:
Per maggiori informazioni:
Food Freshly
Nicola Severo - direttore vendite per l'Italia
+49 1511 0 40 74 94
[email protected]
www.food-freshly.eu










